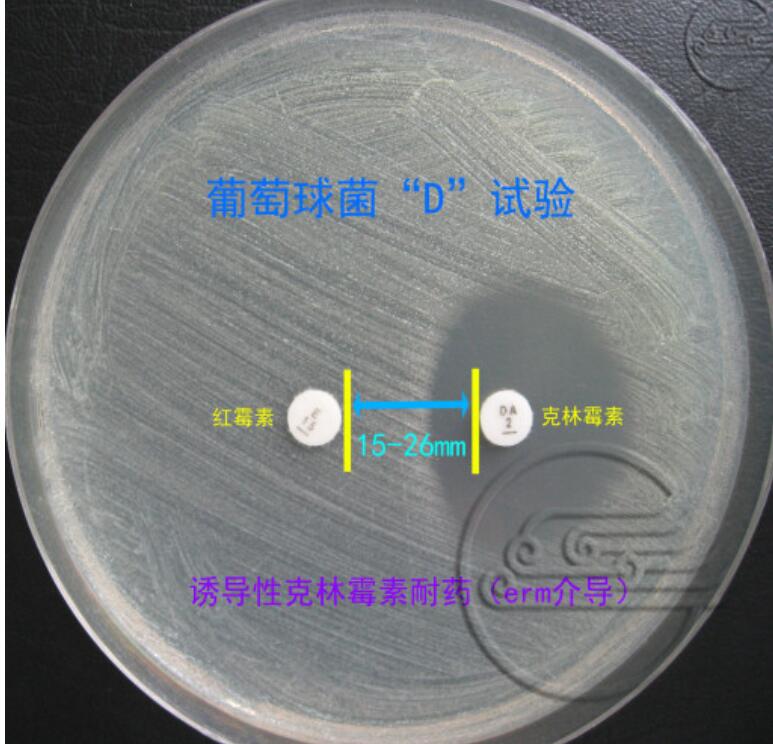
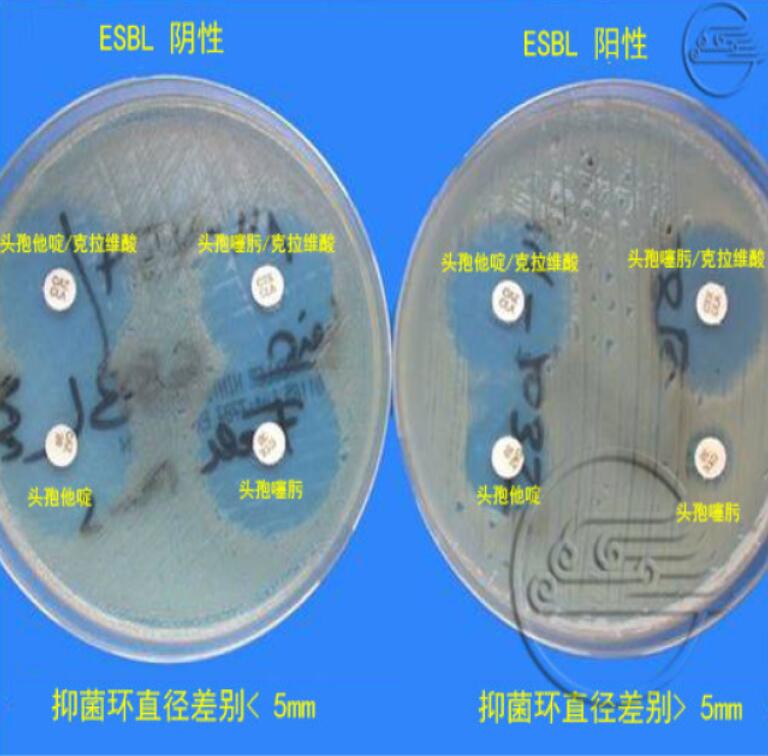
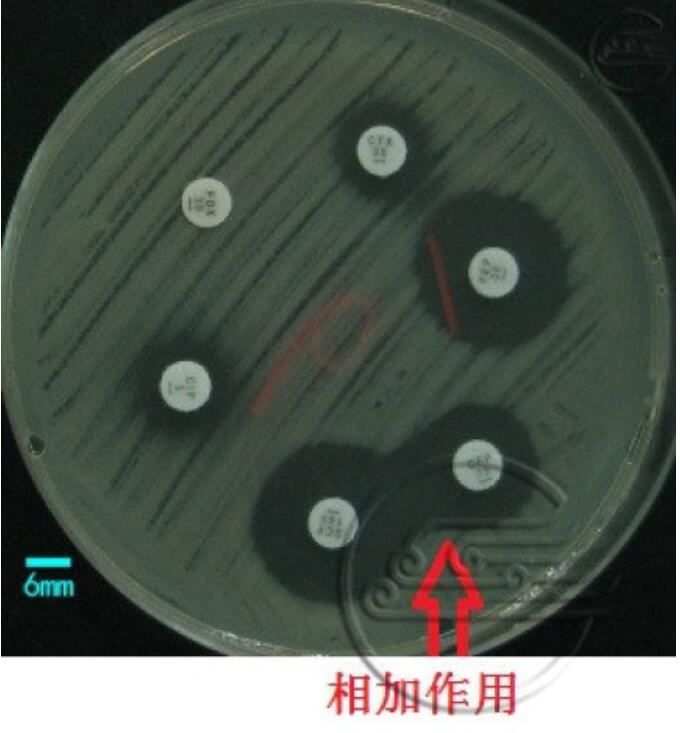
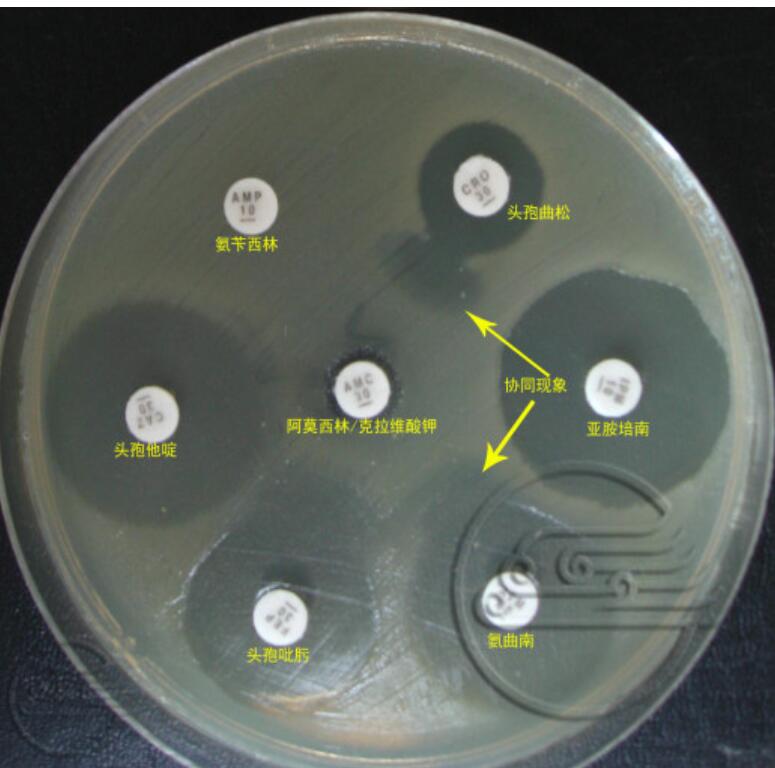
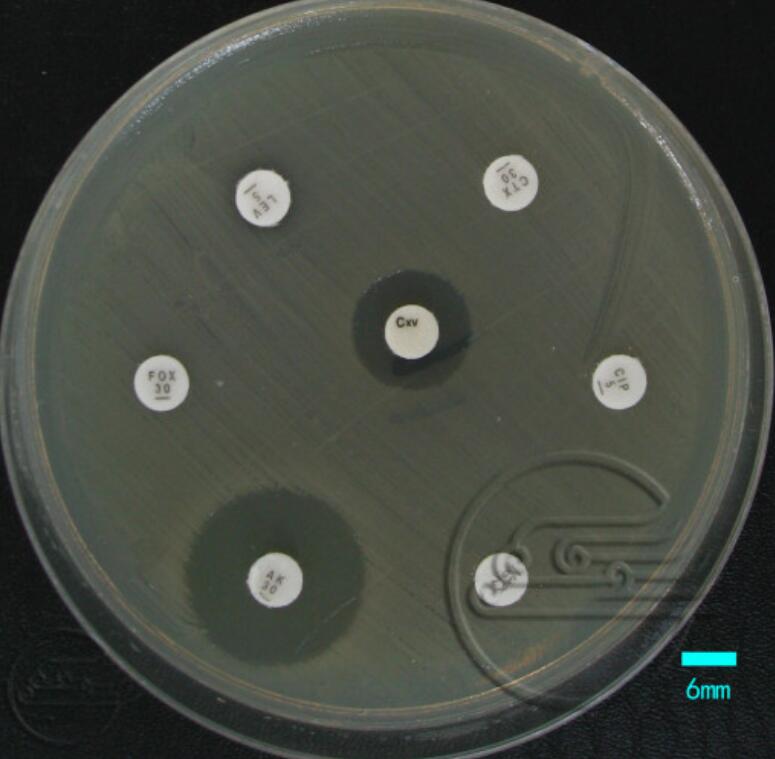

第六章 细菌对抗菌药物敏感性与耐药性
-
1 教学PPT
-
2 微课(课程录像)
-
3 教学图片
-
4 教学案例
-
5 本章小结
-
6 学习参考视频
-
7 自测试题
上一节
下一节